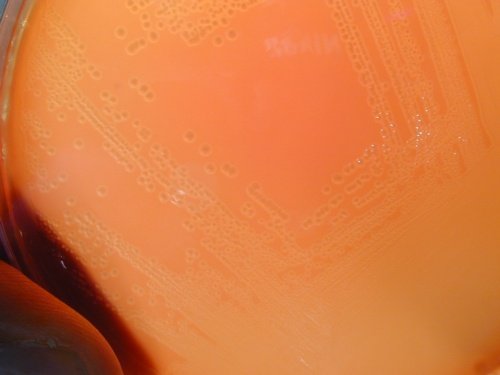
Gelose au sang Streptocoque B
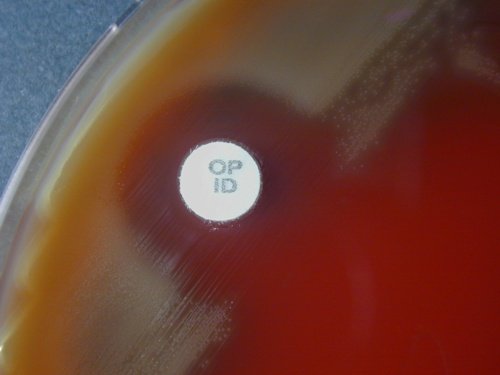
gelose au sang streptococcus pneumoniae optochine
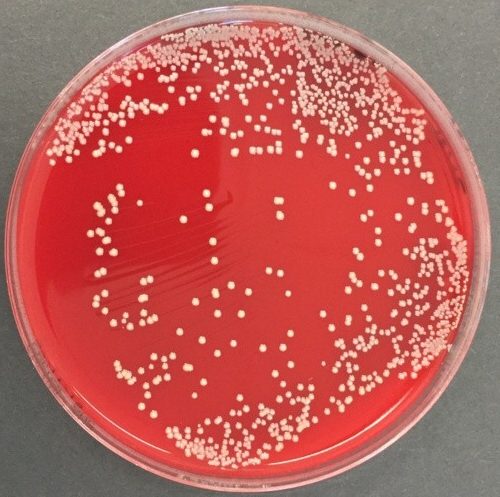
gelose au sang Staphylococcus aureus

La gélose au sang frais, comme son nom l’indique, est constituée d’une base nutritive non sélective à laquelle a été ajoutée 5% de sang frais. Elle convient à la culture de certaines bactéries exigeantes, et permet de mettre en évidence le pouvoir hémolytique de certaines bactéries. Cultivent, par exemple, sur ce milieu, les Streptococcus, Neisseria meningitidis, les corynébactéries et bien sûr toutes les bactéries non exigeantes.
La base nutritive utilisée est le plus souvent une gélose Columbia ou une gélose Trypticase-soja. Ces bases doivent être naturellement isotoniques pour éviter la lyse spontanée des hématies et ne doivent pas contenir de glucose car ce dernier inhibe l’hémolyse par les bactéries.
Le sang frais utilisé est, au préalable, défibriné pour éviter qu’il ne coagule. C’est presque exclusivement du sang de cheval ou de mouton.
La gélose au sang + ANC
C’est une gélose au sang frais rendue sélective des bactéries à Gram positif en ajoutant deux antibiotiques : l’Acide Nalidixique et la Colistine. Cette association d’antibiotique inhibe la très grande majorité des bactéries à Gram négatif.
Elle est particulièrement préconisée pour la recherche des streptocoques mais convient également aux autres bactéries à Gram positif comme les staphylocoques, les corynébactéries, les listéria.
Atmosphère d’incubation
Certains germes, pour lesquels la gélose au sang est préconisée, cultivent mieux en atmosphère enrichie en CO2. C’est le cas tout particulièrement des streptocoques. C’est pourquoi, il est d’usage de les incuber en atmosphère enrichie en CO2.
Les géloses au sang permettent également la culture de nombreuses espèces de bactéries anaérobies strictes, si on a pris soin, bien sûr, d’incuber les boites en anaérobiose.
Étude du caractère hémolytique
Cette étude repose sur l’aspect du milieu autour des colonies. Cet aspect dépend de 2 phénomènes :
- la lyse des hématies par les toxines bactériennes
Le milieu devient plus ou moins tranparent.- transparence totale dans le cas d’une hémolyse complète
- léger trouble dans le cas d’une hémolyse partielle
- la digestion plus ou moins complète de l’hémoglobine libérée
La couleur du milieu dépendra du niveau de digestion de l’hémoglobine.- il retrouve la couleur d’origine de la base nutritive (jaune clair) quand la digestion est complète
- il présente une coloration verdâtre lorsque la digestion de l’hémoglobine est incomplète.
Schématiquement, on décrit 2 types d’hémolyse : l’hémolyse α et l’hémolyse β
L’hémolyse α est une hémolyse partielle avec une dégradation incomplète de l’hémoglobine. Le milieu autour de la colonie n’est pas transparent et présente une couleur verdâtre. Cette zone d’hémolyse est généralement étroite et à bords flous
L’hémolyse β est une hémolyse totale avec une digestion complète de l’hémoglobine. Le milieu autour de la colonie est transparent et présente la couleur de la base nutritive (jaune clair) . Cette zone d’hémolyse est assez souvent large et à bords nets.
En conservant cette description schématique, les aspects de ces deux types d’hémolyse sont représentés ci-dessous.
Schéma d’une hémolyse β |
Schéma d’une hémolyse α |
Le caractère hémolytique est particulièrement utile dans la démarche d’identification des streptocoques. Selon les espèces, ils sont α, β ou non hémolytiques. Pour la plupart des souches de Streptocoques, l’étude du caractère hémolytique ne pose pas de problème.
Notons toutefois que le caractère β hémolytique des streptocoques B n’est pas toujours évident. En effet, la zone d’hémolyse β est très souvent étroite avec une hémolyse partielle (mais pas de verdissement de la gélose).
Exemples de cultures sur gélose au sang
Hémolyse β |
Hémolyse αCulture de Streptococcus pneumoniae sur gélose au sang 24h à 37°C en atmosphère enrichie en CO2 |
![]() Hémolyse β (discrète) Culture de Streptocoque B sur gélose au sang 24h à 37°C en atmosphère enrichie en CO2 |
Hémolyse αCulture de Streptococcus pneumoniae sur gélose au sang 24h à 37°C en atmosphère enrichie en CO2 |
![]() Hémolyse β Culture de Streptocoque C (colonie muqueuse) sur gélose au sang 24h à 37°C en atmosphère enrichie en CO2 |
![]() Hémolyse α Culture de Streptococcus pneumoniae (colonie muqueuse) sur gélose au sang 24h à 37°C en atmosphère enrichie en CO2 |
![]() Pas d’hémolyse Culture de Staphylococcus aureus sur gélose au sang 24h à 37°C en atmosphère enrichie en CO2 |
![]() Hémolyse β (partielle) Culture d’Arcanobacterium haemolyticum sur gélose au sang 24h à 37°C en atmosphère enrichie en CO2 |
![]() Pas d’hémolyse Culture de Pseudomonas aeruginosa sur gélose au sang 24h à 37°C en atmosphère enrichie en CO2 |
![]() Pas d’hémolyse Culture de Klebsiella pneumoniae sur gélose au sang 24h à 37°C en atmosphère enrichie en CO2 |
![]() Pas d’hémolyse Culture de Moraxella catarrhalis sur gélose au sang 24h à 37°C en atmosphère enrichie en CO2 |
|